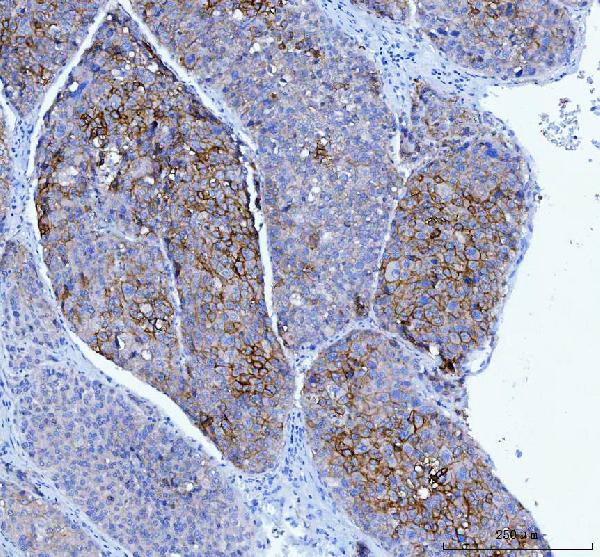

Anti-Poliovirus Receptor/PVR Antibody Picoband™ (monoclonal, 3B11E9)
- SPECIFICATION
- CITATIONS
- PROTOCOLS
- BACKGROUND

Application
| WB, IHC, FC |
|---|---|
| Primary Accession | P15151 |
| Host | Mouse |
| Isotype | Mouse IgG2b |
| Reactivity | Human, Mouse |
| Clonality | Monoclonal |
| Format | Lyophilized |
| Description | Anti-Poliovirus Receptor/PVR Antibody Picoband™ (monoclonal, 3B11E9) . Tested in Flow Cytometry, IHC, WB applications. This antibody reacts with Human, Mouse. |
| Reconstitution | Adding 0.2 ml of distilled water will yield a concentration of 500 µg/ml. |
| Gene ID | 5817 |
|---|---|
| Other Names | Poliovirus receptor, Nectin-like protein 5, NECL-5, CD155, PVR, PVS |
| Calculated MW | 70-80 kDa |
| Application Details | Western blot, 0.25-0.5 µg/ml, Human Immunohistochemistry(Paraffin-embedded Section), 2-5 µg/ml, Human, Mouse Flow Cytometry, 1-3 µg/1x10^6 cells, Human |
| Contents | Each vial contains 4 mg Trehalose, 0.9 mg NaCl and 0.2 mg Na2HPO4. |
| Clone Names | Clone: 3B11E9 |
| Immunogen | E.coli-derived human Poliovirus Receptor/PVR recombinant protein (Position: D28-E331). |
| Purification | Immunogen affinity purified. |
| Storage | At -20°C for one year from date of receipt. After reconstitution, at 4°C for one month. It can also be aliquotted and stored frozen at -20°C for six months. Avoid repeated freezing and thawing. |
| Name | PVR |
|---|---|
| Synonyms | PVS |
| Function | Mediates NK cell adhesion and triggers NK cell effector functions. Binds two different NK cell receptors: CD96 and CD226. These interactions accumulates at the cell-cell contact site, leading to the formation of a mature immunological synapse between NK cell and target cell. This may trigger adhesion and secretion of lytic granules and IFN-gamma and activate cytotoxicity of activated NK cells. May also promote NK cell-target cell modular exchange, and PVR transfer to the NK cell. This transfer is more important in some tumor cells expressing a lot of PVR, and may trigger fratricide NK cell activation, providing tumors with a mechanism of immunoevasion. Plays a role in mediating tumor cell invasion and migration. |
| Cellular Location | [Isoform Alpha]: Cell membrane; Single-pass type I membrane protein [Isoform Beta]: Secreted. |

Thousands of laboratories across the world have published research that depended on the performance of antibodies from Abcepta to advance their research. Check out links to articles that cite our products in major peer-reviewed journals, organized by research category.
info@abcepta.com, and receive a free "I Love Antibodies" mug.
Provided below are standard protocols that you may find useful for product applications.
Background
CD155 (cluster of differentiation 155) also known as the poliovirus receptor is a protein that in humans is encoded by the PVR gene. The protein encoded by this gene is a transmembrane glycoprotein belonging to the immunoglobulin superfamily. The external domain mediates cell attachment to the extracellular matrix molecule vitronectin, while its intracellular domain interacts with the dynein light chain Tctex-1/DYNLT1. The gene is specific to the primate lineage, and serves as a cellular receptor for poliovirus in the first step of poliovirus replication. Multiple transcript variants encoding different isoforms have been found for this gene.
If you have used an Abcepta product and would like to share how it has performed, please click on the "Submit Review" button and provide the requested information. Our staff will examine and post your review and contact you if needed.
If you have any additional inquiries please email technical services at tech@abcepta.com.





Foundational characteristics of cancer include proliferation, angiogenesis, migration, evasion of apoptosis, and cellular immortality. Find key markers for these cellular processes and antibodies to detect them.
The SUMOplot™ Analysis Program predicts and scores sumoylation sites in your protein. SUMOylation is a post-translational modification involved in various cellular processes, such as nuclear-cytosolic transport, transcriptional regulation, apoptosis, protein stability, response to stress, and progression through the cell cycle.
The Autophagy Receptor Motif Plotter predicts and scores autophagy receptor binding sites in your protein. Identifying proteins connected to this pathway is critical to understanding the role of autophagy in physiological as well as pathological processes such as development, differentiation, neurodegenerative diseases, stress, infection, and cancer.